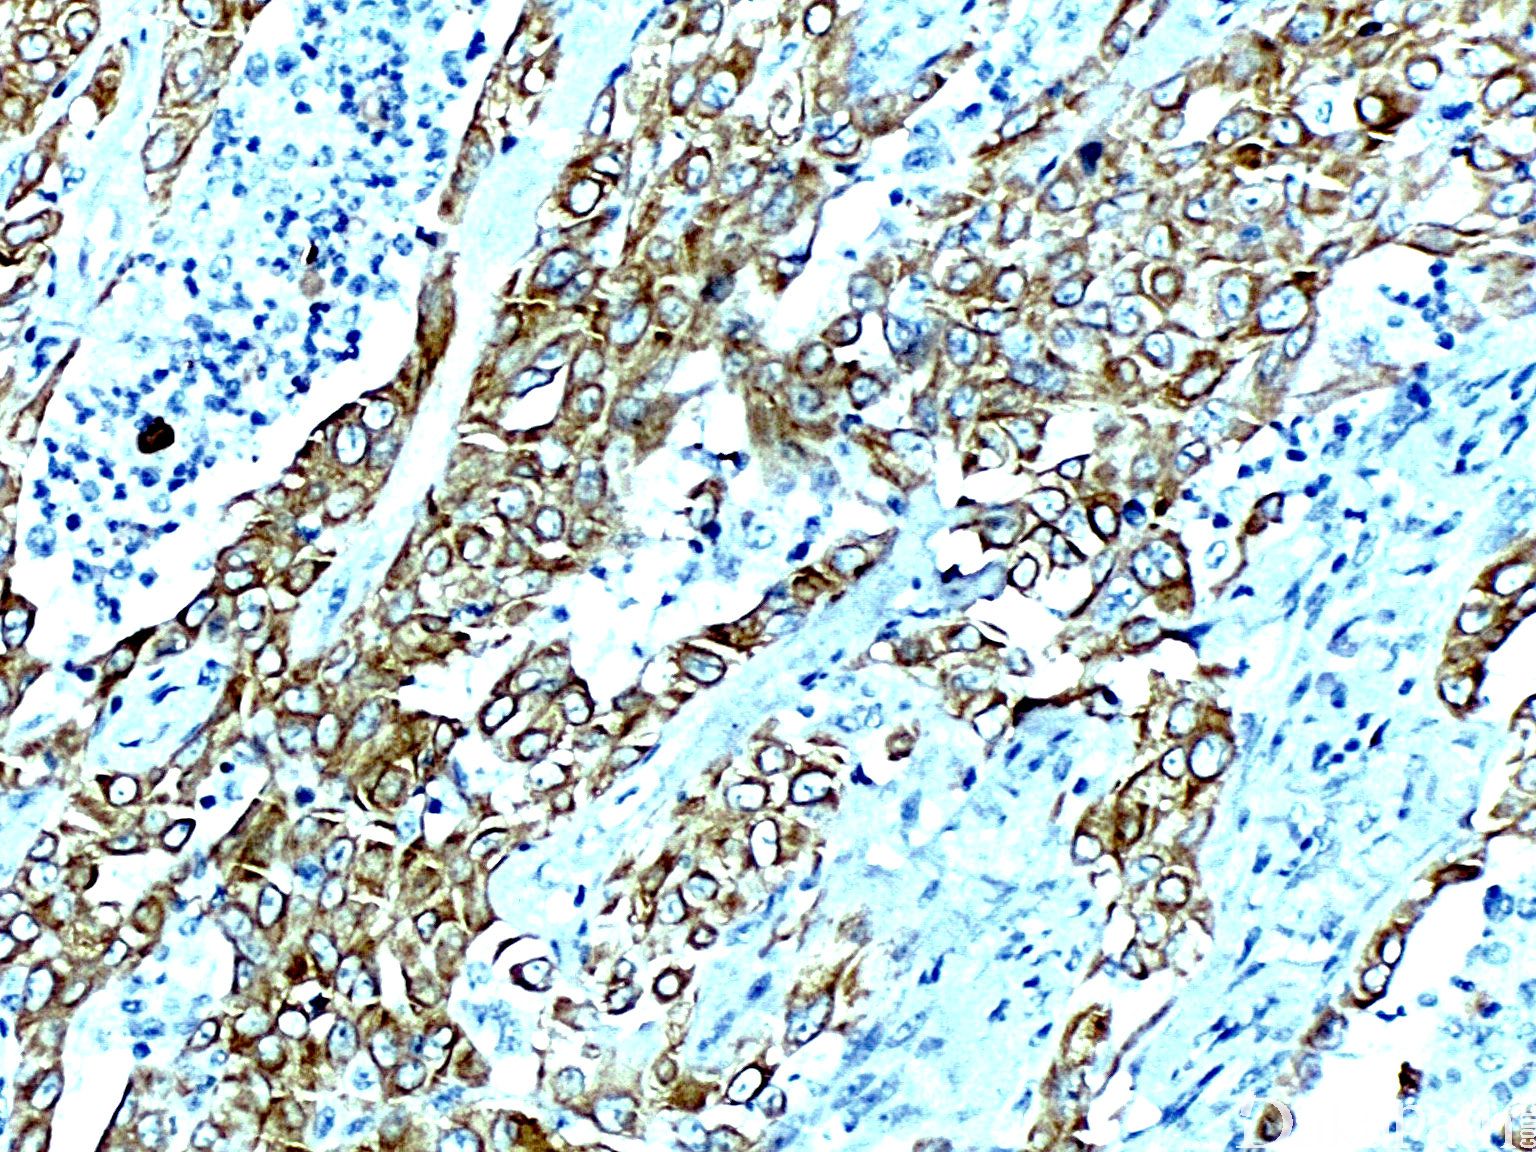

CAM5.2

别名: KER 10.11
概述:
是常用的极低分子量角蛋白,对应 CK7 与 CK8,与 CK7 反应相对较弱,正常分泌上皮阳性,复层鳞状上皮阴性,常与 CK18 联用。
信号定位: 胞质
在病理学中的应用:
上皮源性肿瘤的确定;
与高分子量角蛋白联用,鉴别腺癌和鳞状细胞癌。
商品化试剂(排名不分先后,本网站对抗体质量不负责!)
公司 | 克隆号 | 即用型(ml) | 原液(ml) | ||||
赛诺特 | CAM5.2 | 1 | 3 | 6 | / | 0.1 | 0.2 |
中杉金桥 | CAM5.2 | 1.5 | 3 | 6 | / | 0.1 | 0.2 |
安必平 | CAM5.2 | 1.5 | 3 | 6 | / | 0.1 | 0.2 |
基因科技 | CAM5.2 | 1 | 2 | 4 | 7 | 0.2 | 1 |
